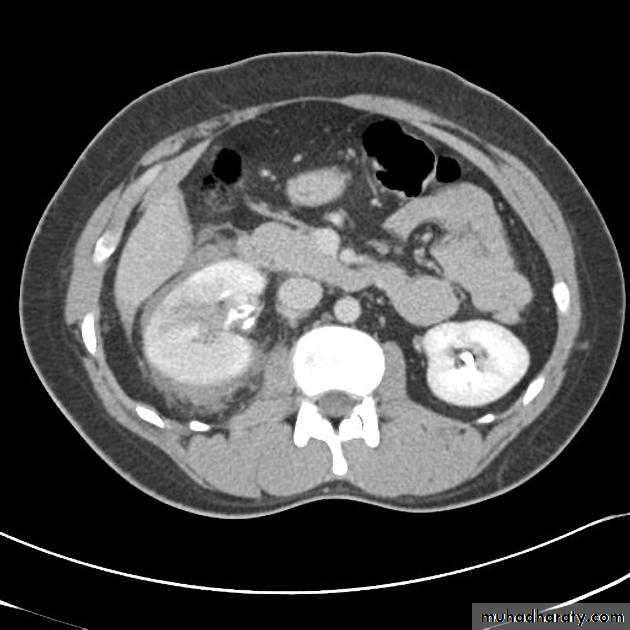

Urinary Tract Imaging
ultrasound,intravenous urography (IVU),
computed tomography (CT) .
MRI
Antegrade &retrograde pyelography.
Voiding cystogram
radionuclide examinations.
Ultrasound, CT and MRI are essentially used for anatomical information; the functional information they provide is limited.
The converse is true of radionuclide examinations where functional information is paramount.
The IVU provides both functional and anatomical information
Renal ultrasound
• US is the 1st line investigation.Normal renal ultrasound shows:
• Smooth renal outlines• Renal parenchyma is of homogenous echoes that is similar or less reflective than the adjacent liver or spleen.
• Renal parenchymal surround the central echo complex.
• PCS and ureters are normally not visible
Intravenous Pyelogram (IVU)
The IVU series consist of:1-KUB film…To identify any calcification like stones or nephrocalcinosis.
2-Post contrast film…
• Check that the kidneys are in their normal positions (the left is usually higher than the right)
• Identify renal outlines…For any bulge or indentation.
• Measure the renal length (10-16 cm) these are higher than those for renal size on ultrasound.
• Calyces should be evenly distributed and symmetrical.
• Its shape is normally cupped , when dilated becomes clubbed.
• The normal renal pelvis is funnel shaped
• The ureters are usually seen in only part of their length on any one film of an IVU.
• The bladder is centrally located and should be smooth in outlines.
Often show normal smooth indentations from above due to uterus or sigmoid colon.
-After micturition the bladder should be empty apart from little contrast trapped in the folded mucosa.
KUB
The post contrast series:
IV access is required for administration of the contrast material.The contrast dose is usually instilled at a fast (bolus) rate.
The calyces are usually not visualised in <2 minutes following contrast administration - This is the NEPHROGRAM phase.
Serial images are taken at 5-20 minutes for visualisation of the PCS and ureters…This is the PYELOGRAM or EXCRETORY phase.
Lastly take a full bladder and a post-void film.
IVU
Normal excretory phase of an IVU (intravenous urogram). This film was taken approximately 10 minutes following IV injection of iodinated contrast material. The kidneys are excreting contrast into non dilated calyces (arrows), renal pelvis (p), ureters (*) and bladder (B).
Cortico-medullary phase: After 35-40 seconds:
The only parts of the renal tract which have enhanced are the renal arteries and the cortex.Useful for evaluation of the renal arteries (which may be reformatted as CT angiogram) and for evaluation of highly vascular renal tumors.
Native CT…For evaluation of any renal stones or abnormal calcification.
CT scanContrast enhanced CT scan through the kidneys in nephrogram phase 90-100 seconds following contrast administration and would show renal lesions well.
Contrast enhanced CT scan through the kidneys in pyelogram phase (showing excretion of contrast into the collecting system). This is approximately 10-15 minutes following contrast administration and would show urothelial lesions well, such as transitional cell carcinoma, stones, blood clots.
• Calcification is not visible on MRI which is one of the main disadvantages for renal tract imaging.
• Generally used in selected circumstances:
• Renal artery stenosis
• IVC or renal vein extension of renal tumors.
• Extent of bladder or prostate cancers before surgery.
-CMD is best with T1 and immediately following IV gadolinium.
-PCS, ureter and bladder are best seen by T2 .
-Heavily weighted T2 is used to acquire MRU.
MRI
Renal MRA
Antegrade&Retrograde pyelographyTheir indications are limited to situations where the information cannot be achieved by less invasive means like IVU or CT to confirm a possible TCC in renal pelvis or ureter.
Voiding cystogram
• The UB is filled with iodinated contrast medium through a catheter… Films are taken during voiding via a fluoroscopy
• Indications are :
• Identify VUR
• Posterior uretheral valve
• Demonstrate the posterior urethera.
Ascending or retrograde urethrogram
Best to visualize and assess the anterior urethra
CALCULIMost renal stones are calcified and show varying density on plain x-ray films.
Pure uric acid & xanthine stones are radiolucent on plain radiography, but are well seen at CT or US.
Plain film is more sensitive than US for detecting ureteric calculi.
Stones regardless their composition are intensely echogenic (By U/S) and cast acoustic shadows
IVU excretory phase showing marked dilated PCS , but normal ureter …
DX congenital PUJ obstruction.Renal masses
Almost all renal parenchymal masses are either simple cysts or malignant tumors(in adults RCC, in young children the commonest is Wilm’s tumor.Other causes of renal masses are benign masses like AML “Angiomyolipoma” , abscesses, hydatid and metastasis.
US can establish wheather a mass is a simple cyst (ignore it)or solid mass (mostly RCC)
Causes of multiple renal masses include:
• Multiple simple cysts
• Polycystic disease.
• Lymphoma.
• Metastasis.
• Inflammatory masses.
Simple cysts
Very common.
Filled with clear fluid(i.e anechoic).
Show obvious echoes from the front and back walls and posterior acoustic enhancement.
Most are spherical in shape.
Imperceptible walls
Solitary or multiple ,unilocular (simple)or have septations (not a simple cyst)
If contain low level echoes in dependent portion complicated by Hhg or infection.
No further investigations are needed.
Angiomyolipoma
• Most common benign solid renal masses.• Usually an incidental finding.
• Contain fat thus hyperechoic on US, fat density/intensity on CT and MRI (their fatty content allows confident dx).
RENAL CELL CARCINOMA(RCC)
Most common malignant renal masses.Spherical or lobulated similar density to the adjacent renal cortex.
May have areas of necrosis.
Enhances heterogeneously and less than that of the adjacent renal parenchyma.
CT is sufficiently accurate so that preoperative biopsy is rarely performed.
Staging is best by CT except for vascular invasion where MRI will be superior.
Staging parameters include : local direct spread, retroperitoneal L.Ns enlargement, liver adrenal or pancreatic metastasis and renal vein or IVC involvement.
Urothelial tumors
Almost all tumors that arise in the PCS are TCC.Sometimes occur at multiple sites (so both PCSs and ureters should be examined).
IVU plays important role in their Dx.
Difficult to be seen by US because it blends with the sinus fat.
Ddx of TCC on IVU are stones and blood clots.
Urinary tract infections(UTI)
• Acute pyelonephritis is usually due to bacterial infection coming from the urethra.• Stones, anatomical abnormalities (eg. Bifid collecting system &horseshoe kidney) vesico-ureteric reflux , obstructive lesions and conditions like D.M. are all predisposing factors.
• In adults only selected cases require imaging.
• In children ,once UTI is confirmed, all patients should have imaging investigations of the renal tract to identify an abnormality such as reflux , which can lead to renal damage if left untreated.
Renal TB
• Blood born usually from pulmonary TB focus.• In early stages , US & IVU may be normal, later on various signs may develop:
• Irregularity of the calyx (the earliest change)
• Stricures of PCS or ureter may occur , the multiplicity of strictures is an important diagnostic feature.
• Calcification is common (initially focal, later on the whole kidney is calcified “Autonephrectomy”).
• In the bladder cause thick wall small volume bladder.
Renal trauma
• The kidneys is one of the frequent abdominal organs to be injured.• 75% due to blunt trauma and 25% due to penetrating injury.
• Loin pain and hematuria are the major presenting features.
• CT scan with contrast is the investigation of choice. It can :
• Demonstrate the perfusion status to the injured kidney.
• Ensure that the opposite kidney is normal.
• Show the extent of renal parenchymal damage.
• Demonstrate injuries to other organs.
Bladder trauma
Intraperitoneal UB rupture(25%) :Result from direct blow to a distended UB.
Leaking of contrast to the peritoneal cavity
Extraperitoneal rupture (75%) :
Associated with pelvic bones fracture.
Congenital anomalies
Bifid collecting system :• The most common encountered anomaly.
• The two ureters may join at any level or may insert separately into the UB. In this case the ureter draining the upper moiety may drain outside the UB e.g. into vagina or urethra, such ureter is known as ectopic ureter.
Ectopic kidney:
• Often incidental finding.
• Usually located in the lower abdomen and the kidney is malrotated.
• Increase incidence of stones formation, hydronephrosis and chronic pyelonephritis.
Horseshoe kidney:
• The kidneys fail to separate and they are almost invariably joined at their lower poles.
• Causes increase incidence of PUJ obstruction and stones formation.
ADPKD:
• Familial disorder
• Age (35-55 years)
• Presented with HTN, renal failure and hematuria.
• Bilateral disease.
• Cysts may also be seen in other organs like liver and pancreas .
pROSTATE
BPH
Very common in elderly men
Occur in the central zone of the prostate.
Prostatic adenocarcinoma:
US cannot differentiate benign from malignant diseases.It is usually located in the peripheral zone.
Prostatic calcification
It is so common that can be regarded as normal finding in elderly.It shows no correlation with the patient’s symptoms and does not have any relation to prostatic CA.